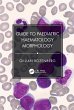
Guide to Paediatric Haematology... - Bild 1

Guide to Paediatric Haematology Morphology (eBook, ePUB)
Versandkostenfrei!
Sofort per Download lieferbar
78,95 €
inkl. MwSt.
Weitere Ausgaben:

PAYBACK Punkte
39 °P sammeln!
This illustrated guide to identifying or confirming blood disorders in paediatric patients presents examples of the abnormal morphology involved. Clinicians in both haematology and paediatrics will find this an invaluable resource.
- Provides an authoritative visual guide for standard morphology in paediatric haematology disorders.
- Offers a reliable guide for registrars in haematology and paediatrics.
- Presents expert guidance for clinical identification and confirmation of diagnoses.
Dieser Download kann aus rechtlichen Gründen nur mit Rechnungsadresse in A, B, BG, CY, CZ, D, DK, EW, E, FIN, F, GR, HR, H, IRL, I, LT, L, LR, M, NL, PL, P, R, S, SLO, SK ausgeliefert werden.